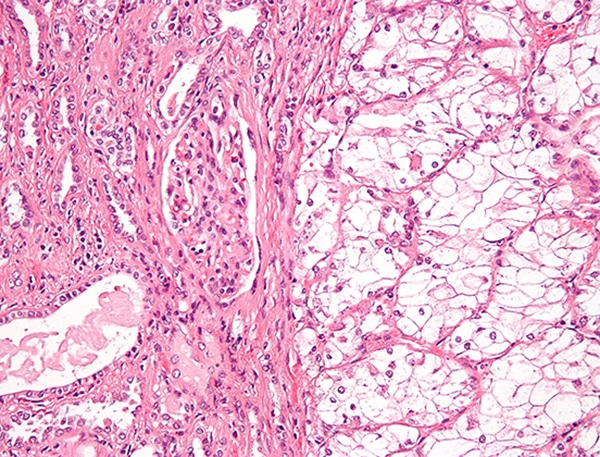

Targeting Advanced Kidney Cancer
The FDA approved the molecularly targeted therapeutic tivozanib to treat certain adult patients with the most common type of kidney cancer.
The U.S. Food and Drug Administration (FDA) has approved tivozanib (Fotivda) to treat adult patients with relapsed or refractory advanced renal cell carcinoma, which is the most common form of kidney cancer. Tivozanib is indicated for patients who have undergone two or more prior systemic therapies.
Tivozanib belongs to a class of targeted therapy agents known as VEGFR kinase inhibitors designed to block the action of certain proteins that help tumors grow.
The data to evaluate the efficacy of tivozanib came from a randomized, open-label, multicenter trial of tivozanib versus sorafenib, which is another VEGFR kinase inhibitor. The patients involved in the study had all received treatment with at least two prior systemic treatments that included a different VEGFR kinase inhibitor from the two offered in the study.
The median progression-free survival was 5.6 months for the patients in the tivozanib arm of the study compared with 3.9 months for the patients treated with sorafenib. The median overall survival was 16.4 months for the patients who received tivozanib versus 19.2 months for the patients who received sorafenib. The objective response rate was 18 percent for the group receiving tivozanib and 8 percent for patients in the sorafenib arm of the study.
Renal cell carcinoma is a kidney cancer that originates in the lining of the proximal convoluted tubule, a part of the very small tubes in the kidney. It usually occurs in people between the ages of 60 and 70 and tends to be more common in males.
The FDA rendered its decision on March 10, 2021.